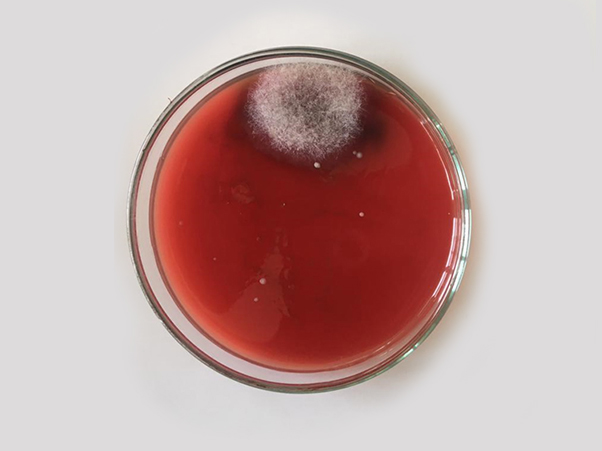
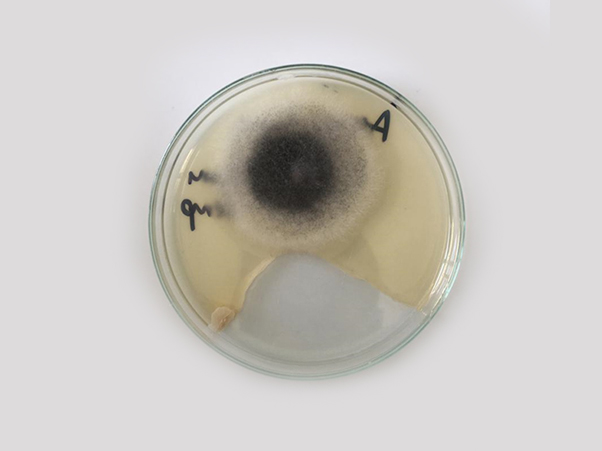
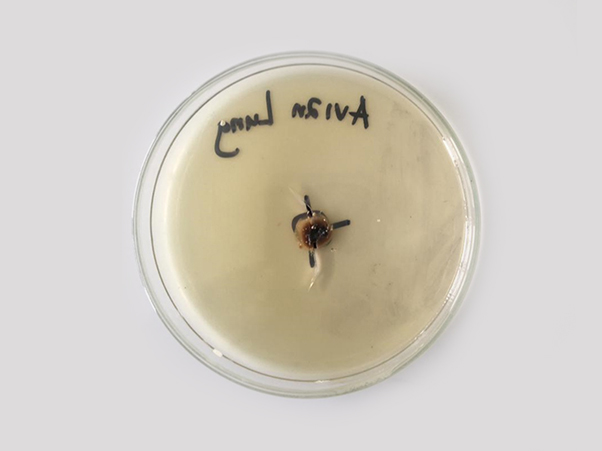

We are importing animal feed additives, for now we have started with Premix Concentrate.
We are serving some animal feed millers in Tanzania.
As one of the duty of VECAB, in 16 June, 2021 we assisted farmers to diagnose some diseases problem in their flock. These farmers were facing by the following signs;
According to the history from the two farmers is that, they though it’s a problem of minerals in the feeds and then they supplied them with mineral supplements but then the problem were still there. Hence VECAB took a responsibility to take blood samples to Laboratory for further investigation of the problem.
Sample Collecting: Experts from VECAB are taking blood samples from broiler chicken for lab analysis.Laboratory Activities
Moleculary Testing
Micro-biology Testing
The followings are the package for feed mill quality control trainings provided by VECAB CONSULTING AND TRADING LTD.
- Sample collection, Sample Storage and Sample Processing
- Materials Quality control
- Production line Quality control
- Finished feed Quality Control
- Laboratory Analysis
- Feed mill online Data system
- Standard Operation Procedure (SOP) In Quality control
We conducted feed mill quality control training to one of our client NUTRIFEED AFRICA to its plant in Dar es salaam and Arusha. See the images below.
A privately owned company that deals with Consulting farmers and feed millers worldwide.
We also deals with trading of agricultural and livestock inputs as well as agricultural and livestock products.
Quick Links
External Links
Contact Us
Address:
Plot No. 3855, Bunju B
P.O. Box 67406,
Dar es Salaam - Tanzania Phone: +255679159159
+255768159159
Email: info@vecab.co.tz